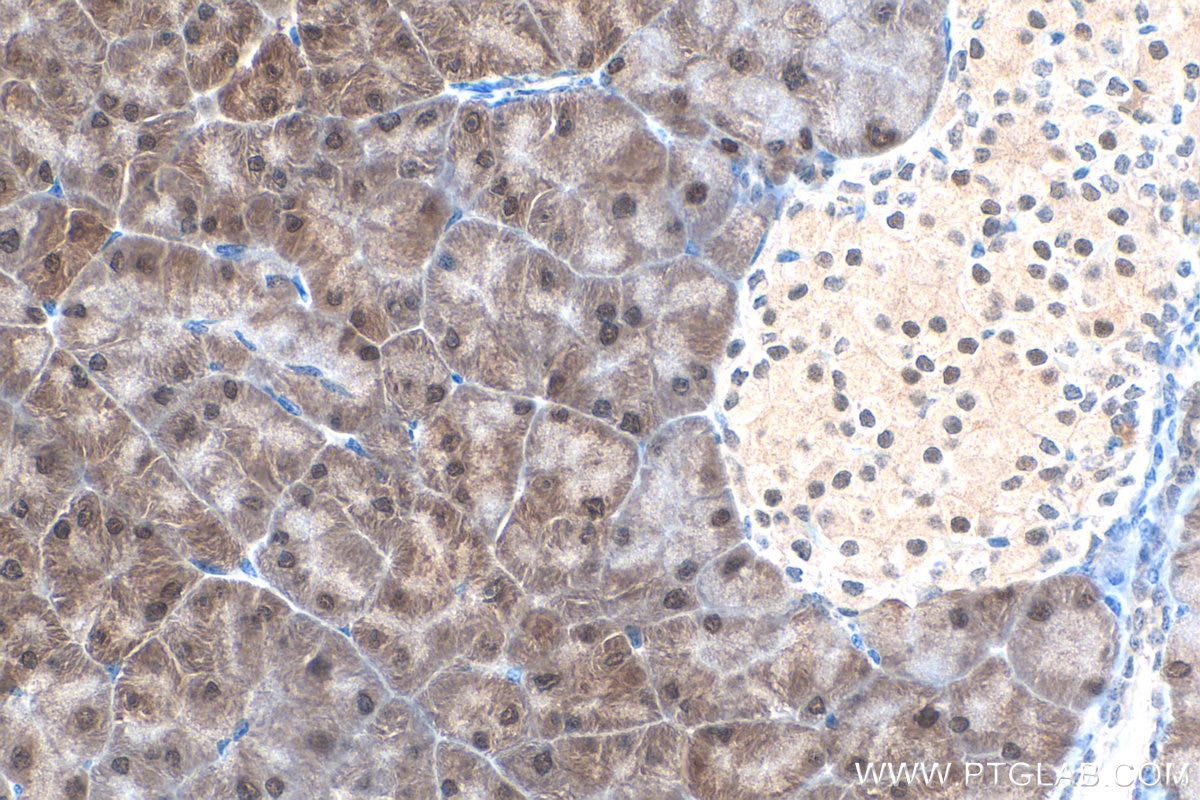
Immunohistochemistry (IHC) staining of mouse pancreas tissue using SEPHS2 Polyclonal antibody (14109-1-AP)
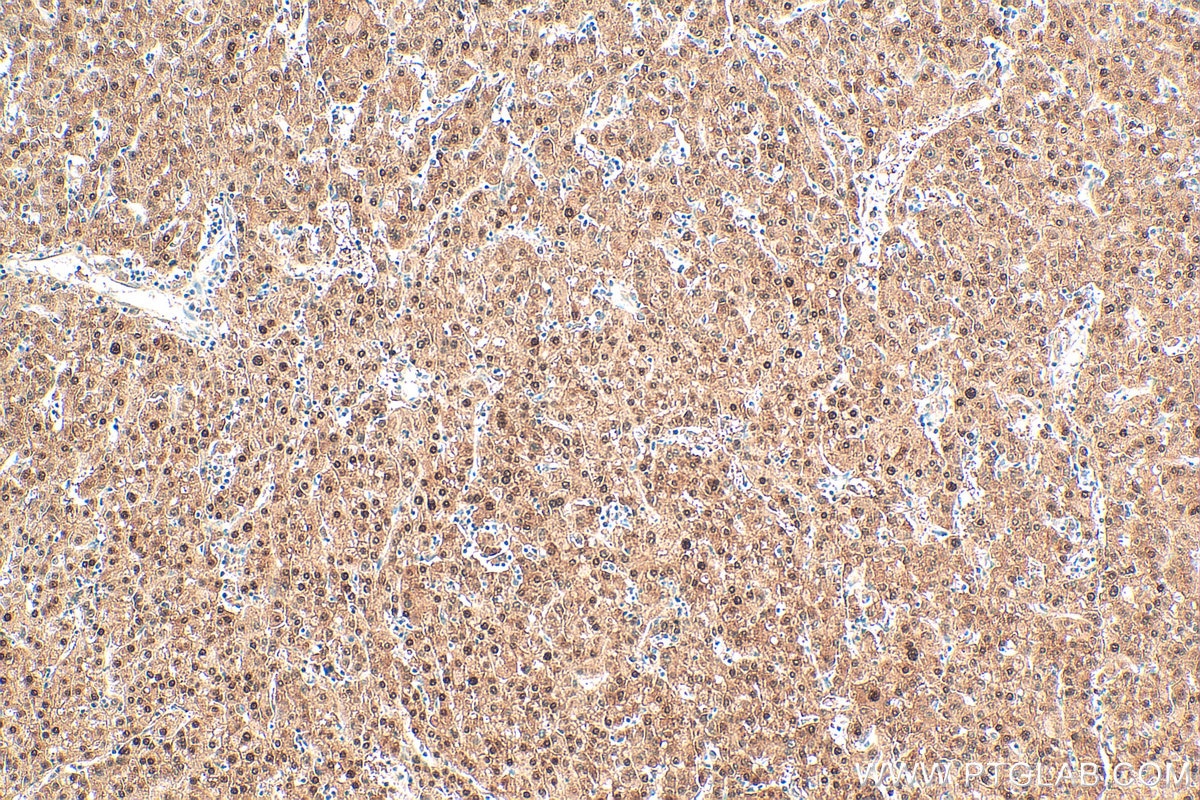
Immunohistochemistry (IHC) staining of human liver cancer tissue using SEPHS2 Polyclonal antibody (14109-1-AP)

Tested Applications
| Positive WB detected in | NCI-H1299 cells, mouse pancreas tissue, mouse adipose tissue, rat liver tissue |
| Positive IHC detected in | mouse pancreas tissue, human breast cancer tissue, human liver cancer tissue Note: suggested antigen retrieval with TE buffer pH 9.0; (*) Alternatively, antigen retrieval may be performed with citrate buffer pH 6.0 |
Recommended dilution
| Application | Dilution |
|---|---|
| Western Blot (WB) | WB : 1:1000-1:4000 |
| Immunohistochemistry (IHC) | IHC : 1:750-1:3000 |
| It is recommended that this reagent should be titrated in each testing system to obtain optimal results. | |
| Sample-dependent, Check data in validation data gallery. | |
Published Applications
| WB | See 5 publications below |
| IHC | See 1 publications below |
Product Information
14109-1-AP targets SEPHS2 in WB, IHC, ELISA applications and shows reactivity with human, mouse, rat samples.
| Tested Reactivity | human, mouse, rat |
| Cited Reactivity | human, mouse |
| Host / Isotype | Rabbit / IgG |
| Class | Polyclonal |
| Type | Antibody |
| Immunogen |
CatNo: Ag5255 Product name: Recombinant human SEPHS2 protein Source: e coli.-derived, PGEX-4T Tag: GST Domain: 118-448 aa of BC016643 Sequence: GMDSCVIPLRHGGLSLVQTTDFFYPLVEDPYMMGRIACANVLSDLYAMGITECDNMLMLLSVSQSMSEEEREKVTPLMVKGFRDAAEEGGTAVTGGQTVVNPWIIIGGVATVVCQPNEFIMPDSAVVGDVLVLTKPLGTQVAVNAHQWLDNPERWNKVKMVVSREEVELAYQEAMFNMATLNRTAAGLMHTFNAHAATDITGFGILGHSQNLAKQQRNEVSFVIHNLPIIAKMAAVSKASGRFGLLQGTSAETSGGLLICLPREQAARFCSEIKSSKYGEGHQAWIVGIVEKGNRTARIIDKPRVIEVLPRGATAAVLAPDSSNASSEPSS Predict reactive species |
| Full Name | selenophosphate synthetase 2 |
| Calculated Molecular Weight | 47 kDa |
| Observed Molecular Weight | 47-50 kDa |
| GenBank Accession Number | BC016643 |
| Gene Symbol | SEPHS2 |
| Gene ID (NCBI) | 22928 |
| RRID | AB_2878014 |
| Conjugate | Unconjugated |
| Form | Liquid |
| Purification Method | Antigen affinity purification |
| UNIPROT ID | Q99611 |
| Storage Buffer | PBS with 0.02% sodium azide and 50% glycerol, pH 7.3. |
| Storage Conditions | Store at -20°C. Stable for one year after shipment. Aliquoting is unnecessary for -20oC storage. 20ul sizes contain 0.1% BSA. |
Background Information
SEPHS2 (Selenophosphate synthetase 2), a selenophosphate synthetase, catalyzes the conversion of selenite and adenosine triphosphate (ATP) into selenophosphate. SEPHS2 is the rate-limiting enzyme that converts selenite to selenocysteine, a key substance in the synthesis of many selenium proteins such as glutathione peroxidase, thioredoxin reductase, and formate dehydrogenase (PMID: 40750759, 31695102).
Protocols
| Product Specific Protocols | |
|---|---|
| IHC protocol for SEPHS2 antibody 14109-1-AP | Download protocol |
| WB protocol for SEPHS2 antibody 14109-1-AP | Download protocol |
| Standard Protocols | |
|---|---|
| Click here to view our Standard Protocols |
Publications
| Species | Application | Title |
|---|---|---|
Mol Cell PRDX6 dictates ferroptosis sensitivity by directing cellular selenium utilization | ||
Biomaterials H2Se-evolving bio-heterojunctions promote cutaneous regeneration in infected wounds by inhibiting excessive cellular senescence | ||
Redox Biol Macrophages and macrophage extracellular vesicles confer cancer ferroptosis resistance via PRDX6-mediated mitophagy inhibition | ||
EMBO Mol Med Breast cancer secretes anti-ferroptotic MUFAs and depends on selenoprotein synthesis for metastasis | ||
Front Med (Lausanne) A glycometabolic gene signature associating with immune infiltration and chemosensitivity and predicting the prognosis of patients with osteosarcoma | ||
Nat Struct Mol Biol PRDX6 augments selenium utilization to limit iron toxicity and ferroptosis |